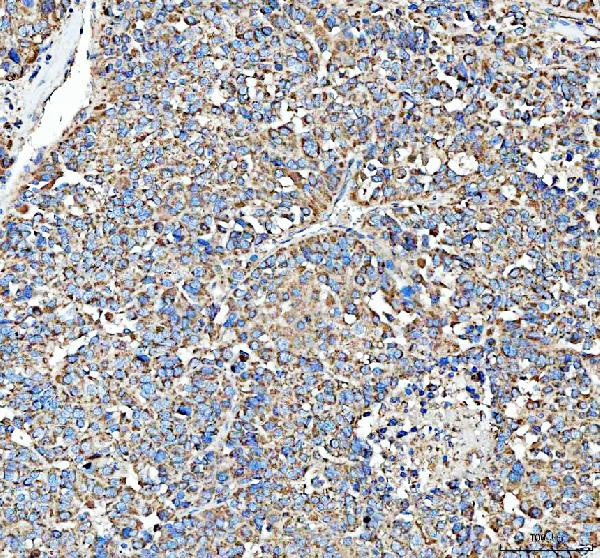
HSD11B1 Antibody in Immunohistochemistry (Paraffin) (IHC (P))

Search
Invitrogen
HSD11B1 Polyclonal Antibody
{{$productOrderCtrl.translations['antibody.pdp.commerceCard.promotion.promotions']}}
{{$productOrderCtrl.translations['antibody.pdp.commerceCard.promotion.viewpromo']}}
{{$productOrderCtrl.translations['antibody.pdp.commerceCard.promotion.promocode']}}: {{promo.promoCode}} {{promo.promoTitle}} {{promo.promoDescription}}. {{$productOrderCtrl.translations['antibody.pdp.commerceCard.promotion.learnmore']}}
图: 1 / 4
HSD11B1 Antibody (PA5-79398) in IHC (P)




Please note: We are reviewing Western blot images included in the antibody testing data in our catalog, including those provided by third parties. Unless expressly labeled or annotated as “raw-unedited”, Western blot images included in the antibody testing data in our catalog may have been edited, optimized or otherwise adjusted for presentation.
产品信息
PA5-79398
种属反应
宿主/亚型
分类
类型
抗原
偶联物
形式
浓度
规格
纯化类型
保存液
内含物
保存条件
运输条件
RRID
产品详细信息
Reconstitute with 0.2 mL of distilled water to yield a concentration of 500 µg/mL.
Positive Control - WB: human hepatocellular carcinoma tumor tissue, human hepatocellular carcinoma paracancerous tissue, monkey liver tissue, rat liver tissue, mouse liver tissue. IHC: human liver cancer tissue.
靶标信息
HSD11B1 is a microsomal enzyme that catalyzes the conversion of the stress hormone cortisol to the inactive metabolite cortisone. In addition, HSD11B1 can catalyze the reverse reaction, the conversion of cortisone to cortisol. Too much cortisol can lead to central obesity, and a particular variation in this gene has been associated with obesity and insulin resistance in children. The protein encoded by this gene is a microsomal enzyme that catalyzes the conversion of the stress hormone cortisol to the inactive metabolite cortisone. In addition, the encoded protein can catalyze the reverse reaction, the conversion of cortisone to cortisol. Too much cortisol can lead to central obesity, and a particular variation in this gene has been associated with obesity and insulin resistance in children. Two transcript variants encoding the same protein have been found for this gene.
仅用于科研。不用于诊断过程。未经明确授权不得转售。
篇参考文献 (0)
生物信息学
蛋白别名: 11-beta-HSD1; 11-beta-HSD1A/MCR; 11-beta-hydroxysteroid dehydrogenase 1; 11-beta-hydroxysteroid dehydrogenase/microsomal carbonyl reductase; 11-DH; 11beta-HSD-1; 11beta-HSD1A; 11beta-hydroxysteroid dehydrogenase type 1; 7-oxosteroid reductase; Corticosteroid 11-beta-dehydrogenase isozyme 1; Corticosteroid 11-beta-dehydrogenase, isozyme 1 (11-DH) (11-beta-hydroxysteroid dehydrogenase 1) (11-beta-HSD1) (11beta-HSD1A); cortocosteroid 11-beta dehydrogenase; hydroxysteroid dehydrogenase, 11 beta type 1; liver-type 11-beta-HSD; MGC13539; OTTHUMP00000034650; Short chain dehydrogenase/reductase family 26C member 1
基因别名: HSD11; HSD11B1; HSD11L; LRRGT00065; SDR26C1
UniProt ID: (Rat) P16232, (Mouse) P50172
Entrez Gene ID: (Rat) 25116, (Mouse) 15483